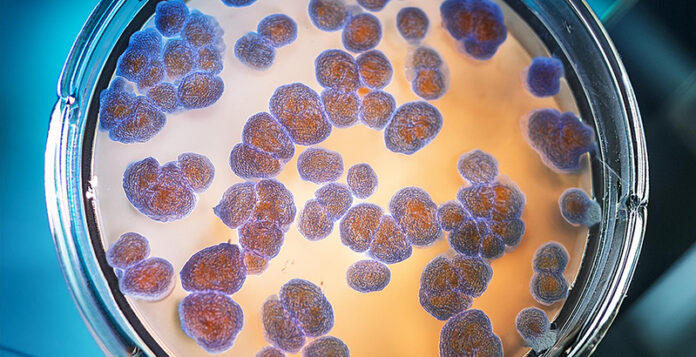

Fibroblasti e acido ialuronico, lo studio
Fibroblasti e acido ialuronico, lo studio. Esponiamo qui una sintesi della tesi di laurea specialistica in medicina estetica del dott. Mattia Ivo Lamanna dal titolo: Trattamento di patologie con defluvio non cicatriziale del cuoio capelluto mediante tricobiostimolazione e medical device a base di fibroblasti e acido ialuronico. Il test clinico Il test ha visto l’arruolamento … Leggi tutto Fibroblasti e acido ialuronico, lo studio
0 Commenti